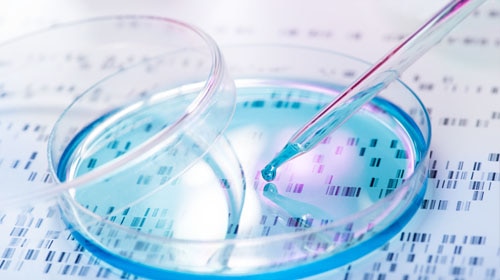

While chemical products provide many benefits to society, they must also be managed responsibly to minimize any adverse effects on humans and the environment. Dow employees take this responsibility very seriously and work hard to ensure that Dow's products are designed, stored, transported, used, disposed of or recycled in a manner that shows high regard for human health, safety and environmental stewardship. Dow's product safety organization includes over 200 experts in global chemical and end-use regulations, product stewardship, toxicology (human and environmental), risk assessment, and hazard communication. This organization ensures that Dow's materials are compliant with regulations and safe to use in their intended applications. This is the basis of how we bring materials safely to the market through innovation and collaboration.
Ever wondered how Dow brings new innovations to the marketplace and what steps take place to ensure its safety? Watch Dow's Product Safety Story.